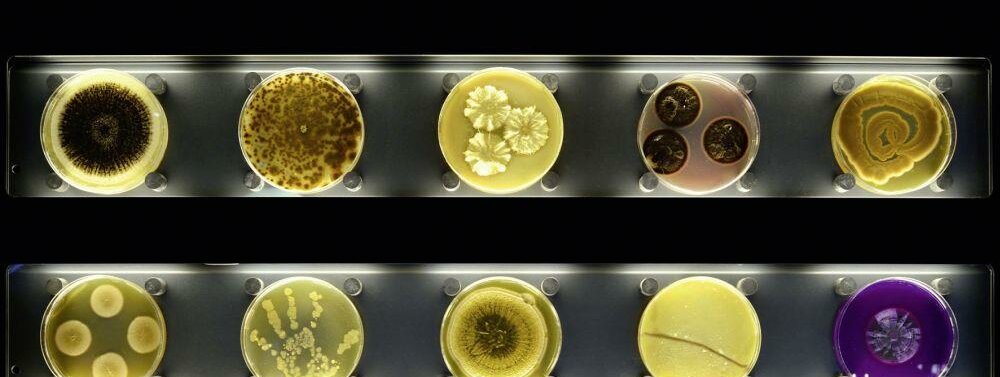

Schon mal da gewesen?
MIKROBENZOO IN AMSTERDAM
Seite 1/1 2 Minuten
Die Idee zu Micropia kam Haig Balian, seit 2003 Direktor von Natura Artis Magistra in Amsterdam, kurz: Artis, dem ältesten Zoo der Niederlande und der Welt, während er an einem Entwurf für den Tierpark des 21. Jahrhunderts arbeitete. Er war überzeugt, dass Artis zu seiner grundlegenden Erneuerung den ersten Zoo für Mikroorganismen eröffnen müsse.
Verwirklichung einer Vision Statt wie üblich in einem Zoo verschiedene Arten zu zeigen, will der Ökologe die Zusammenhänge der Natur in ihrer Gesamtheit sichtbar machen. Micropia zeigt das Unsichtbare. Die meisten Mikroorganismen sind mit bloßem Auge nicht zu erkennen. Aus Unkenntnis haben viele Menschen Vorurteile gegenüber der Mikronatur und assoziieren diese vor allem mit Krankheitserregern. Nicht erschrecken, denn der Bodyscanner im Museum zeigt 172 Quintillionen an. Dies soll genau die Zahl von Mikroorganismen sein, die auf dem menschlichen Körper herumkriechen – bei dieser Vorstellung fängt es bei so manchem Zuhörer an zu jucken.
Tatsächlich bietet der Mensch vielen Milliarden wuseligen Untermietern im Mund, auf den Händen, in den Augen oder im Magen ein Zuhause. Jeder Erwachsene trage durchschnittlich eineinhalb Kilogramm Mikroben mit sich herum, weiß Haig Balian.
Mikroorganismen, die begeistern Micropia möchte mehr sein als ein Museum und sich zu einer internationalen Plattform für Mikrobiologie entwickeln, die die Wissenschaft mit ihren Interessensgruppen verbindet. Das über 140 Jahre alte Reichsmonument de Ledenlokalen am Artisplein wurde um eine Black Box erweitert, in der der obere Teil von Micropia liegt. Der untere Teil befindet sich im hellen Erdgeschoss. Beide verbindet eine Wand, in doppelter Höhe, die aus LCD-Bildschirmen besteht und die Mikroorganismen in ihrem Verhältnis zueinander maßstabsgetreu wieder gibt. Mithilfe von speziellen 3DMikroskopen, die ganz einfach mit Joysticks funktionieren, wird die Welt der Bakterien, Algen, Schimmelpilze und anderer Mikroorganismen den Besuchern anschaulich näher gebracht.
KONTAKT
Micropia, Artisplein (Artisplatz), Plantage Kerklaan 36 – 38,, NL – Amsterdam,
Internet: www.micropia.nl, Öffnungszeiten: So. bis Mi.: 9 bis 18 Uhr, Do. bis Sa.: 9 bis 20 Uhr
Für Besucher ab acht Jahren geeignet.
Interaktiv ist auch die beeindruckende Installation „Bodyscan“, die den Besucher selbst zum Gegenstand der Untersuchung macht. In den 3D-Landschaften können Interessierte die widerstandsfähigen Untermieter in ihren verschiedensten Habitaten besuchen. Eigens dafür gibt es ein mechanisches Rad, mit dem man sich durch die Landschaften bewegen kann. Die Einzigartigkeit von Micropia liegt in der Mischung lebendiger und virtueller Mikroben, die es zu betrachten und erforschen gilt.
Den Artikel finden Sie auch in Die PTA IN DER APOTHEKE 11/14 auf Seite 83.